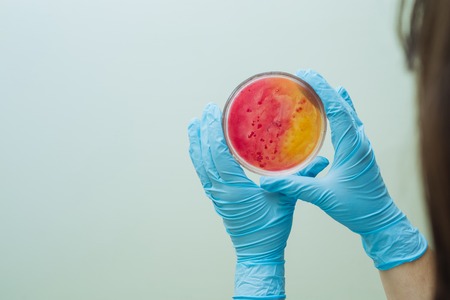
Laboratory technician testing for bacterial infection. Lab worker analyzes test sample in Petri dishes. Bacterial colonies growth. Medical hospital laboratory research. Hand holding test sample. Healthcareの写真素材

写真素材 - Laboratory technician testing for bacterial infection. Lab worker analyzes test sample in Petri dishes. Bacterial colonies growth. Medical hospital laboratory research. Hand holding test sample. Healthcare
作品情報
Laboratory technician testing for bacterial infection. Lab worker analyzes test sample in Petri dishes. Bacterial colonies growth. Medical hospital laboratory research. Hand holding test sample. Healthcare
- ID:70309115
- 作品種別:写真
- 作者名:Oleksii Nazarenko
キーワード
- E coli
- Escherichia
- Petri
- Staphylococcus
- Streptococcus
- agar
- analysis
- bacteria
- bacterial
- biochemistry
- biohazard
- biology
- biotechnology
- colony
- culture
- cure
- diagnostic
- dish
- equipment
- glass
- glassware
- glove
- grow
- growth
- hand
- health
- healthcare
- hold
- horizontal
- hospital
- infection
- lab
- laboratory
- medical
- medicine
- microbe
- microorganism
- overgrowth
- plate
- research
- sample
- science
- scientific
- technician
- test
- testing
- treat
- treatment
- vial
類似作品
young scientist...
Close-up of bac...
Research, exper...
Close-up of bac...
Young Asian res...
Asian laborator...
Research labora...
Bacterial Inocu...
Gloved Hand of ...
Close up the me...
Bacterial Inocu...
Hands, sample a...
Scientist analy...
Laboratory assi...
chemist wearing...
A person in a p...
Researcher work...
Microbiology co...
Scientist weari...
Close up crop v...
Hands in blue g...
Workspace of a ...
Bacterial Inocu...
Scientist hand ...
Gloved Hand of ...
Young male chem...
Making bacterio...
Overhead view o...
Gloved Hand of ...
Laboratory assi...
Working table w...
Forensic invest...
female science ...
Scientist holdi...
Scientist worki...
Laboratorian wo...
Woman experimen...
Scientist worki...
Streak plate fo...
Scientist worki...
Microbiology La...
portrait of mus...
Blurred of scie...
A striking, hig...
Microbiology la...
Under the soft ...
Scientist Condu...
Biologist resea...
The hands of a ...